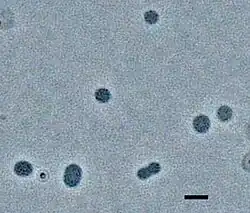

Thermococcus
| Thermococcus | ||||||||||||
|---|---|---|---|---|---|---|---|---|---|---|---|---|

Thermococcus sp. | ||||||||||||
| Systematik | ||||||||||||
| ||||||||||||
| Wissenschaftlicher Name | ||||||||||||
| Thermococcus | ||||||||||||
| Zillig 1983 |
Thermococcus ist eine Gattung thermophiler Archaeen in der Familie Thermococcaceae.[3][5]
Thermococcus-Mitglieder werden als heterotrophe, chemotrophe[6][7][8] und auch als organotrophe „Sulfanogene“ beschrieben; sie nutzen Kohlenstoffquellen wie Aminosäuren, Kohlenhydrate und organische Säuren (wie Brenztraubensäure) Pyruvat sowie elementaren Schwefel.[7][8][9]
Morphologie
Die Mitglieder der Gattung Thermococcus sind typischerweise unregelmäßig geformt bis mehr oder weniger sphärisch (kokkoid) mit einem Durchmesser von 0,6 bis 2,0 μm.[6]
Einige Thermococcus-Arten sind unbeweglich, andere Arten sind beweglich, indem sie Geißeln (Archaellen) als Hauptbewegungsmittel nutzen. Diese Geißeln befinden sich in der Regel an einem bestimmten Pol der Zelle. Eine solche Bewegung wurde je nach Art und Stamm bei Raumtemperatur oder bei hohen Temperaturen beobachtet.[10]
Bei einigen Arten können diese Mikroorganismen aggregieren und weiß-graue Plaques bilden.[11]
Habitat
Arten der Gattung Thermococcus gedeihen in der Regel entweder in der Nähe von Süßwasserquellen oder Schwarzen Rauchern (hydrothermalen Schloten)[12] bei Temperaturen zwischen 60 und 105 °C (beim hohen Wasserdruck in der Tiefsee),[13], wobei die optimale Temperatur bei 85 °C liegt.[13][14][15]
Sie sind daher thermophil[6][16] und auch strikt anaerob.[17][16] Sie kommen in verschiedenen Tiefen vor, z. B. in hydrothermalen Schloten 2.500 m unter der Meeresoberfläche,[18] oder in geothermischen Quellen nur Zentimeter unter der Wasseroberfläche.[19] Sie gedeihen bei einem pH-Wert von 5,6 bis 7,9.[20] Natriumchlorid ist an diesen Orten in der Regel in einer Konzentration von 1 % bis 3 % vorhanden,[17] dies ist aber kein notwendiges Substrat für diese Organismen,[21][22] Thermococcus-Mitglieder leben in heißen Süßwassersystemen auf der Nordinsel Neuseelands.[12] Sie benötigen jedoch eine niedrige Konzentration von Lithiumionen für ihr Wachstum.[23]
Mitglieder dieser Gattung wurden in vielen hydrothermalen Schloten auf der ganzen Welt gefunden (kosmopolitisch), unter anderem in den Meeren Japans[24] im Golf von Kalifornien.[6] aber auch in den heißen Quellen im Flachwasser um die italienische Indes Vulcano.
Stoffwechsel
Für die Glykolyse (Zuckerabbau) benutzen die Thermococcus-Arten einen anderen Stoffwechselweg als Eukaryoten und auch andere Prokaryoten.[25][13] Ein anderer wichtiger Stoffwechselweg bei diesen Organismen ist der Abbau von Peptiden. Dieser verläuft in drei Schritten: Zunächst werden die Peptide durch Peptidasen zu Aminosäuren hydrolysiert. Dann bewerkstelligen Aminotransferasen die Umwandlung der Aminosäuren in Ketosäuren, und schließlich wird mit Hilfe von vier weiteren Enzymen bei der oxidativen Decarboxylierung der Ketosäuren Kohlendioxid (CO2) freigesetzt, wobei Coenzym-A-Derivate entstehen, die in anderen wichtigen Stoffwechselwegen Verwendung finden.[13][25] Thermococcus-Arten verfügen auch über das Enzym RuBisCO (Ribulose-1,5-Bisphosphat-Carboxylase/Oxygenase).[26] Dieses wird bei Thermococcus kodakarensis aus Enzymen hergestellt, die am Stoffwechsel von Nukleinsäuren beteiligt sind.[13][25][26] Das zeigt, wie integriert (eng miteinander in Verbindung stehend) diese Stoffwechselsysteme bei hyperthermophilen Mikroorganismen wie Thermococcus tatsächlich sind.[26]
Es konnten auch einige Nährstoffe identifiziert werden, die das Zellwachstum von Thermococcus limitieren. Die Nährstoffe, die das Zellwachstum von Thermococcus-Arten am meisten beeinflussen, sind Kohlenstoff- und Stickstoffquellen. Da die Mitglieder von Thermococcus nicht alle erforderlichen Aminosäuren selbst herstellen können, müssen einige von der Umgebung, in der diese Organismen gedeihen, bereitgestellt werden (Thermococcus-spezifische essentielle Aminosäuren). Einige dieser Aminosäuren sind die verzweigtkettigen Aminosäuren Leucin, Isoleucin und Valin Wenn den Thermococcus-Arten diese Aminosäuren zugeführt werden, werden sie verstoffwechselt, wobei Acetyl-CoA oder Succinyl-CoA entsteht. Diese beiden Koenzyme sind wichtige Voraussetzungen für andere Stoffwechselwege, darunter solche, die für das Zellwachstum und die Zellatmung Voraussetzung sind.[26]
Der Spezies Thermococcus onnurineus fehlen dagegen die Gene für die Purinnukleotid-Biosynthese.[26] Diese Art ist daher zur Deckung ihres Purinbedarfs auf Umweltquellen angewiesen ist.[27]
Kultivierung
Mit heutigen Methoden lassen sich die Thermococcus-Arten im Allgemeinen relativ leicht im Labor züchten,[28] weshalb diese als Modellorganismen für die Untersuchung der physiologischen und molekularen Wege von Extremophilen dienen.[29][30] Insbesondere ist Thermococcus kodakarensis ein solches Beispiel für einen Thermococcus-Modellorganismus; das gesamtes Genom dieser Spezies ist sequenziert und untersucht worden.[30][31][32]
Ökologie
Die extreme Hyperthermophile verschafft ihnen einen großen ökologischen Vorteil, denn so sind sie die ersten Organismen, die neue hydrothermale Umgebungen besiedeln.[13][14][15] Thermococcus-Arten sind sogar auf die extremen Umweltbedingungen angewiesen: neben der hohen Temperatur meist auch extreme pH-Werte und Salzkonzentrationen. Unter solchen Bedingungen produzieren sie Stressproteine und molekulare Chaperone, die ihre DNA und den zellulären „Haushalt“ (Stoffwechselapparat) schützen. Thermococcus-Arten gedeihen auch unter glukoneogenen Bedingungen.
Einige Thermococcus-Arten produzieren Kohlendioxid (CO2), Wasserstoff (Diwasserstoff; H2) und Schwefelwasserstoff (H2S) als Stoffwechsel- und Atmungsprodukte.[30] Die freigesetzten Moleküle werden dann von anderen autotrophen Arten genutzt und tragen so zur Vielfalt der hydrothermalen Mikrobengemeinschaften bei. Diese Art von natürlicher kontinuierlicher Anreicherungskultur spielt eine entscheidende Rolle in der Ökologie der Hydrothermalquellen in der Tiefsee. Anscheinend interagieren die Thermococcus-Arten mit den anderen Organismen über den Austausch von Metaboliten, was das Wachstum dieser anderen Organismen fördert.[33][13]
Genetik

Transport-Mechanismen, Gentransfer, Kommunikation
Thermococcus-Arten sind von Natur aus in der Lage, DNA aufzunehmen und solche Spender-DNA durch homologe Rekombination in ihr Genom einzubauen.[34] Diese Arten können Membranvesikel (MVs) produzieren, die durch Knospung aus den äußersten Zellmembranen gebildet werden,[34][35] Diese können Plasmide von benachbarten Archaeen-Arten einfangen und diese DNA entweder in sich selbst integrieren oder an benachbarte Arten übertragen.[34] Diese MVs werden in Clustern aus den Zellen abgesondert und bilden Nanokugeln oder Nanoröhren,[35] wobei die inneren Membranen durchlässig bleiben.[34] Die Fähigkeit zum DNA-Transfer und zur Integration von Spender-DNA in das (eigene oder fremde) Empfängergenom durch homologe Rekombination ist bei Archaeen weit verbreitet und scheint eine Anpassung zur Reparatur von DNA-Schäden in den Empfängerzellen zu sein (siehe auch Archaeen, §Gentransfer). Thermococcus-Arten produzieren zahlreiche MVs, die DNA, Metaboliten und bei einigen Arten sogar Toxine übertragen.[35] Darüber hinaus schützen diese MVs ihren Inhalt vor thermischem Abbau, indem sie die Makromoleküle in eine geschützte Umgebung bringen. übertragen.[34][35] Neben diesem Transport von Makromolekülen verhindern MVs auch Infektionen, indem sie Viruspartikel einfangen.[35] Darüber hinaus nutzen Thermococcus-Arten MVs (Nanoröhren) zur Kommunikation untereinander.[34] Beispielsweise werden MVs von der Art Thermococcus coalescens verwendet, um untereinander zu kommunizieren, wann eine Aggregation stattfinden soll, so dass die typischerweise einzelligen Mikroorganismen zu einer großen Einzelzelle (Größe 5 Mikrometer) verschmelzen können.[34][36]
DNA-Replikation
Der Prozess der DNA-Replikation und -Verlängerung wurde bei T. kodakarensis eingehend untersucht. Das DNA-Molekül dieser Art ist zirkuläre und hat eine Länge von etwa 2 Millionen Basenpaaren; es enthält mehr als~2.000 Proteine kodierende Sequenzen.[37]
Plasmide, Virus-ähnliche Gensequenzen und Viren
2012/2013 wurde über vier virusähnliche Abschnitte (englisch virus-like integrated gene elements) im Genom von Thermococcus kodakarensis berichtet, die für Subtilisin-ähnliche Serinprotease-Vorläufer kodieren.[10][38][39]
Möglicherweise sind nicht alle dieser virusähnlichen Elemente ins Hauptgenom integriert! sondern Plasmid-ähnliche extrachromosomales Elemente, so etwa das bei dieser Spezies gefundene TKV1. TKV1 zeigte Homologie zum extrachromosomalen Element pAMT11 von Thermococcus sp. AMT11, sowie eine entfernte Ähnlichkeit zu einem Plasmid von Pyrococcus sp. JT1.[40]
Bis 2012 wurden Archaeen der Familie Thermococcaceae nur zwei Viren isoliert:[41]
- Thermococcus prieurii virus 1 (TPV1), Wirt: Thermococcus prieurii Stamm Bio-pl-0405IT2[42]
- Pyrococcus abyssi virus 1 (PAV1), Wirt: Pyrococcus abyssi Stamm GE23[43]
Die TPV1-Partikel haben eine zitronenförmige Morphologie (140 nm × 80 nm). TPV1 könnte wie auch PAV1 zu der Virusfamilie Fuselloviridae angehören. TPV1 enthält eine doppelsträngige zirkuläre DNA von 21,5 kbp, dieses Genom umfasst nach Vorhersage 28 Gene. Die Infektion mit TPV1 verursacht keine Lyse des Wirts, die Virusreplikation kann durch UV-Bestrahlung ausgelöst werden.[41]
Anwendung
Thermococcus-Arten, die mit Hilfe mehrerer Hydrogenasen (einschließlich CO-abhängiger Hydrogenasen) H2 freisetzen, werden als potenzielle Biokatalysatoren für Wassergas-Shift-Reaktionen angesehen.[44]
Eines der Thermococcus-Enzym, die DNA-Polymerase Tpa-S von T. kodakarensis, hat sich 2013 bei der Polymerase-Kettenreaktion (PCR) als effizienter erwiesen als die bis dahin etablierte Taq-Polymerase des Bakteriums Thermus aquaticus.[38] Tk-SP, ein weiteres Enzym aus T. kodakarensis, kann abnorme Prionproteine (PrPSc) abbauen[A. 1][38][45] Tk-SP weist eine breite Substratspezifität auf und baute Prionen im Labor sehr schnell ab. Dieses Enzym benötigt weder Kalzium noch ein anderes Substrat, um sich zu falten, und zeigt daher in bisherigen Studien ein großes Potenzial.[38]
Weitere Studien wurden zum Enzym Phosphoserin[46]-Phosphatase (PSP) von T. onnurineus veröffentlicht, die eine wesentliche Komponente zu der Regulierung der PSP-Aktivität darstellen. Diese Informationen sind für Arzneimittelhersteller von Nutzen, da eine abnormale PSP-Aktivität zu einem starken Abfall des Serinspiegels im Nervensystem führt, was neurologische Krankheiten und Komplikationen verursacht.[45]
Systematik
Artenliste
Die hier angegebene Artenliste (Stand: 23. August 2024) folgt grundsätzlich der List of Prokaryotic names with Standing in Nomenclature (LPSN)[3]mit wenigen Ergänzungen zu unveröffentlichten Spezies nach der Taxonomie des National Center for Biotechnology Information (NCBI)[A. 2][5] und der Genome Taxonomy Database (GTDB)[A. 3][4] In der GTDB wurde die Gattung jedoch aufgesplittet und mehrere Teile (durch angehängte Buchstaben A, B, C gekennzeichnet) abgetrennt, was hier transparent wiedergegeben ist – gemäß LPSN und NCBI gehören diese Mitglieder alle zur Gattung Thermococcus.
Gattung Thermococcus Zillig 1983 s. s.
- Spezies Thermococcus aciditolerans Li et al. 2021 (in der GTDB ein Synonym von T. celericrescens)
- Referenzstamm SY113 alias JCM 39083, MCCC 1K04190
– vom Südwestindischen Rücken
- Referenzstamm SY113 alias JCM 39083, MCCC 1K04190
- Spezies Thermococcus barossii Duffaud et al. 2005[28]
- Referenzstamm SHCK-94 alias ATCC BAA-1085, DSM 17882, DSM 9535, JCM 12858
– aus Gesteinsfragmenten an der Flanke eines hydrothermalen Schlots des Juan-de-Fuca-Rückens als Teil des Ostpazifischen Rückens
- Referenzstamm SHCK-94 alias ATCC BAA-1085, DSM 17882, DSM 9535, JCM 12858
- Spezies Thermococcus camini Courtine et al. 2021 [Thermococcus sp. IRI35c]
- Referenzstamm Iri35c alias DSM 111003, UBOCC M-2026
– von einem hydrothermalen Tiefseeschlot im Atlantik
- Referenzstamm Iri35c alias DSM 111003, UBOCC M-2026
- Spezies Thermococcus celer Zillig 1983 (Typusart)[47]
- Spezies Thermococcus celericrescens Kuwabara et al. 2007
- Referenzstamm TS2 alias DSM 17994, JCM 13640, NBRC 101555
– aus heißem Wasser, das aus einem in ein Hydrothermalgebiet getriebenen Rohr austritt; Suiyo Seamount, Izu-Bonin-Bogen, Westpazifik südlich von Honshū, Japan
- Referenzstamm TS2 alias DSM 17994, JCM 13640, NBRC 101555
- Spezies Thermococcus cleftensis Hensley et al. 2014
- Referenzstamm CL1 alias DSM 27260, KACC 17922
– aus einem Polychaeten-Wurm der Gattung Paralvinella (Alvinellidae), der von einem Fragment eines Schwarzen Rauchers aus 2350 m Tiefe im Cleft-Segment (Spalten-Bereich) des Juan-de-Fuca-Rückens stammt (nordöstlicher Pazifik).
- Referenzstamm CL1 alias DSM 27260, KACC 17922
- Spezies Thermococcus eurythermalis Zhao et al. 2015
- Referenzstamm A501 alias CGMCC 7834, JCM 30233
– ölhaltiger Schlot im Guaymas-Becken, Golf von Kalifornien
- Referenzstamm A501 alias CGMCC 7834, JCM 30233
- Spezies Thermococcus gammatolerans Jolivet et al. 2003
- Referenzstamm EJ3 alias DSM 15229, JCM 11827
– Probe von einem hydrothermalen Schlot aus 2.616 m Tiefe im Guaymas-Becken, Golf von Kalifornien
- Referenzstamm EJ3 alias DSM 15229, JCM 11827
- Spezies Thermococcus gorgonarius Miroshnichenko et al. 1998[49]
- Referenzstamm W-12 alias ATCC 700654, DSM 10395, JCM 10552
– aus Sand von der Küste von Moutohora Island (alias Whale Island), Neuseeland (Nordinsel)
- Referenzstamm W-12 alias ATCC 700654, DSM 10395, JCM 10552
- Spezies Thermococcus guaymasensis Canganella et al. 1998[6]
- Referenzstamm TYS alias DSM 11113, JCM 10136
– von einem hydrothermalen Schlot aus 2.000 m Tiefe im Guaymas-Becken, Golf von Kalifornien
- Referenzstamm TYS alias DSM 11113, JCM 10136
- Spezies Thermococcus henrietii Alain et al. 2021
- Referenzstamm Ext12c alias DSM 111004, UBOCC M-2417
– von einem hydrothermalen Tiefsee-Schlot des Ostpazifischen Rückens, ca. 925 km südwestlich der Küste Mexikos
- Referenzstamm Ext12c alias DSM 111004, UBOCC M-2417
- Spezies Thermococcus indicus Lim et al. 2021 [Thermococcus sp. IOH1]
- Referenzstamm IOH1 alias JCM 39077, KCTC 15844
– Onnuri vent field (Onnuri-Schlotfeld),[50] Zentralindischer Ozeanrückens
- Referenzstamm IOH1 alias JCM 39077, KCTC 15844
- Spezies Thermococcus kodakarensis corrig. Atomi et al. 2005 [Thermococcus kodakaraensis Atomi et al. 2005, „Pyrococcus kodakaraensis“ Rahman et al. 1998] (Modellorganismus)[51][52][53][54][32][21][24][38][15][55][10][8]
- Referenzstamm KDO1 oder KOD1 alias ATCC BAA-918, JCM 12380
– von einem Unterwasser=Solfatar nahe der Küste der Insel Kodakara, Tokara-Inseln (zu Kagoshima, Japan)[56]
- Referenzstamm KDO1 oder KOD1 alias ATCC BAA-918, JCM 12380
- Spezies Thermococcus nautili Gorlas et al. 2022 [„Thermococcus nautilus“ Soler et al. 2007[57][A. 4]]
- Referenzstamm 30-1 alias CNCM 4275, DSM 112553, JCM 19601
– Ostpazifischer Rücken
- Referenzstamm 30-1 alias CNCM 4275, DSM 112553, JCM 19601
- Spezies „Thermococcus onnurineus“ Bae et al. 2006[11]
- Spezies Thermococcus pacificus Miroshnichenko et al. 1998[44][49]
- Referenzstamm P-4 alias ATCC 700653, DSM 10394, JCM 10553
– Boden-Ablagerungen, Bay of Plenty (Te Moana-a-Toi), Neuseeland (Nordinsel)
- Referenzstamm P-4 alias ATCC 700653, DSM 10394, JCM 10553
- Spezies Thermococcus peptonophilus González et al. 1996
- Referenzstamm OG-1 alias ATCC 700098, CIP 104782, DSM 10343, JCM 9653
– Tiefseehydrothermalschlot im Westpazifik
- Referenzstamm OG-1 alias ATCC 700098, CIP 104782, DSM 10343, JCM 9653
- Spezies Thermococcus piezophilus Dalmasso et al. 2017 [„Thermococcus superprofundus“ Dalmasso et al. 2016]
- Referenzstamm CDGS alias ATCC TSD-33, UBOCC 3296
– Hydrothermaler Schlot, Mexiko
- Referenzstamm CDGS alias ATCC TSD-33, UBOCC 3296
- Spezies Thermococcus profundus corrig. Kobayashi & Horikoshi 1995 Thermus profundus Kobayashi & Horikoshi 1995[25]
- Referenzstamm DT5432 alias ATCC 51592, CIP 105121, DSM 9503, JCM 9378
– von einem Tiefsee-Hydrothermalschlot aus einer Tiefe von 1.395 m, Tiefe 1.395 m im Mittleren Okinawa-Graben (Middle Okinawa Trench (Mid-Okinawa Trough)), Pazifik
- Referenzstamm DT5432 alias ATCC 51592, CIP 105121, DSM 9503, JCM 9378
- Spezies „Thermococcus radiotolerans“ Jolivet et al. 2004
- Referenzstamm EJ2 alias DSM 15228, JCM 11826
– von der Seite eines Hydrothermalschlots eines Hydrothermalfelds im Guaymas-Becken, Golf von Kalifornien
- Referenzstamm EJ2 alias DSM 15228, JCM 11826
- Spezies Thermococcus siculi Grote et al. 2000
- Referenzstamm RG-20 alias ATCC BAA-270, DSM 12349
– Tiefsee-Hydrothermalschlot, im Mittleren Okinawa-Graben (Middle Okinawa Trench (Mid-Okinawa Trough)), Südwest-Pazifik
- Referenzstamm RG-20 alias ATCC BAA-270, DSM 12349
- Spezies Thermococcus stetteri Miroshnichenko 1990
- Referenzstamm K-3 alias DSM 5262, JCM 8559
– Marine Solfatarenfelder der Kraternaya-Bucht[60], Uschischir-Archipel, Nördliche Kurilen
- Referenzstamm K-3 alias DSM 5262, JCM 8559
- Spezies Thermococcus thermotolerans Yang et al. 2023 [Thermococcus sp. 813A4, Thermococcus sp024707485(G)]
- Referenzstamm 813A4 alias JCM 39367, MCCC M28628
– Schlot im südwestlichen Indischen Ozean
- Referenzstamm 813A4 alias JCM 39367, MCCC M28628
- Spezies Thermococcus thioreducens Pikuta et al. 2007[31]
- Referenzstamm OGL-20P alias ATCC BAA-394, DSM 14981, JCM 12859
– aus Schlacken (Sedimentschlamm) des Tiefsee-Hydrothermalschlots Rainbow in 2.300 m Tiefe, Mittelatlantischer Rücken vor der Küste der Azoren
- Referenzstamm OGL-20P alias ATCC BAA-394, DSM 14981, JCM 12859
- Spezies Thermococcus zilligii Ronimus et al. 1999[17]
- Referenzstamm AN1 alias ATCC 700529, DSM 2770, JCM 10554
– anaerober Schlamm aus alkalischen Thermalquellen, Kuirau-Park in Rotorua, Neuseeland (Nordinsel)
- Referenzstamm AN1 alias ATCC 700529, DSM 2770, JCM 10554
- Spezies Thermococcus sp000151205(G) [Thermococcus sp. AM4(N)][61]
- [Referenz]stamm AM4
– aus hydrothermalen Schloten des Ostpazifischen Rückens in 2.600 m Tiefe
- [Referenz]stamm AM4
Gattung Thermococcus_A(G)
- Spezies Thermococcus aggregans Canganella et al. 1998
- Referenzstamm TY alias DSM 10597, DSM 12819, JCM 10137
– Hydrothermalschlot in 2.000&mbsp;m Tiefe im Guaymas-Becken, Golf von Kalifornien
- Referenzstamm TY alias DSM 10597, DSM 12819, JCM 10137
- Spezies Thermococcus alcaliphilus Keller et al. 1997
- Referenzstamm AEDII12 alias DSM 10322
– seichtes marines hydrothermales System bei der Insel Vulcano, Italien
- Referenzstamm AEDII12 alias DSM 10322
- Spezies Thermococcus argininiproducens Park et al. 2023
- Referenzstamm IOH2 alias KCTC 25190, MCCC 4K00089
– vom Zentralindischen Ozeanrücken
- Referenzstamm IOH2 alias KCTC 25190, MCCC 4K00089
- Spezies „Thermococcus bergensis“ Birkeland et al. 2021
- Referenzstamm T7324T alias DSM 27149, KCTC 15808
– Ölplattform in der Nordsee vor Norwegen
- Referenzstamm T7324T alias DSM 27149, KCTC 15808
- Spezies Thermococcus litoralis Neuner et al. 2001
- Referenzstamm NS-C alias ATCC 51850, DSM 5473, JCM 8560
– flache Meeres-Thermalquelle, Neapel, Bucht von Lucrino, Golf von Pozzuoli beu Neapel, Italien
- Referenzstamm NS-C alias ATCC 51850, DSM 5473, JCM 8560
- Spezies Thermococcus sibiricus Miroshnichenko et al. 2001[45]
- Referenzstamm MM 739 alias DSM 12597, VKM B-2774
– Probe des geförderten Wassers (produziertes Abwasser) von der Hochtemperatur-Öllagerstätte Samoltor, Westsibirien, isoliert aus Formationswasser, Hochtemperatur-Öllagerstätte Samoltor, Westsibirien
- Referenzstamm MM 739 alias DSM 12597, VKM B-2774
Gattung Thermococcus_B(G)
- Spezies Thermococcus barophilus Marteinsson et al. 1999
- Referenzstamm MP alias CNCM I-1946, DSM 11836
– Schlackenwand eines hydrothermalen Tiefseeschlots in 3.600 m Tiefe, am Snake Pit, Mittelatlantischer Rücken
- Referenzstamm MP alias CNCM I-1946, DSM 11836
- Spezies Thermococcus paralvinellae Hensley et al. 2014
- Referenzstamm ES1 alias DSM 27261, KACC 17923
– Polychaeten-Wurm der Gattung Paralvinella (Alvinellidae) in einem Fragment eines Schwarzen Rauchers in einer Tiefe von 2.200 m, Endeavour-Segment am Nordende des Juan-de-Fuca-Rückens, nordöstlicher Pazifik
- Referenzstamm ES1 alias DSM 27261, KACC 17923
- Spezies Thermococcus paralvinellae_A(G)
Gattung Thermococcus_C(G)
- Spezies Thermococcus_C sp002009975(G) [Thermococcus sp. JdFR-02]
- Referenzstamm JdFR-02
– Metagenom aus basaltischen Krustenfluiden im Boden an der Flanke des Juan-de-Fuca-Rückens, Pazifik
- Referenzstamm JdFR-02
In der GTDB zur Gattung Pyrococcus:
- Spezies Thermococcus chitonophagus Huber & Stetter 1996 [„Pyrococcus chitonophagus“]
- Referenzstamm GC74 alias DSM 10152
– Heißes Fluid aus einem Tiefsee-Hydrothermalschlot vor der Westküste Mexikos
- Referenzstamm GC74 alias DSM 10152
Ohne Zuordnung zu einer dieser Gattungen in der GTDB
- Spezies Thermococcus acidaminovorans Dirmeier et al. 2001
- Spezies Thermococcus aegaeus corrig. Arab et al. 2000 [Thermococcus aegaeicus Arab et al. 2000]
- Referenzstamm P5 alias DSM 12767, JCM 10828, BK17S6-3-b2
– isoliert aus einem hydrothermalen Meeresschlot, Ägäisches Meer, Palaeochori-Bucht (Paralia Paliochóri), Milos[62]
- Referenzstamm P5 alias DSM 12767, JCM 10828, BK17S6-3-b2
- Spezies Thermococcus atlanticus Cambon-Bonavita et al. 2004
- Referenzstamm MA898 alias DSM 15226, JCM 16138
– hydrothermale Probe von einem Schwarzen Raucher am Mittelatlantischen Rücken (26° N)
- Referenzstamm MA898 alias DSM 15226, JCM 16138
- Spezies Thermococcus coalescens Kuwabara et al. 2005
- Referenzstamm TS1 alias DSM 16538, JCM 12540
– Hydrothermale Flüssigkeit vom Suiyo Seamount, Izu-Bonin-Bogen, Westpazifik südlich von Honshū, Japan[36]
- Referenzstamm TS1 alias DSM 16538, JCM 12540
- Spezies Thermococcus fumicolans Godfroy & Meunier 1996
- Referenzstamm ST557 alias CIP 104680, CIP 104690, DSM 12820, JCM 10128
– Tiefsee-Hydrothermalschlot, nördliche Fischi-Becken (North Fiji Basin, NFB)[63]
- Referenzstamm ST557 alias CIP 104680, CIP 104690, DSM 12820, JCM 10128
- Spezies Thermococcus hydrothermalis Godfroy et al. 1997
- Referenzstamm AL662 alias CNCM I-1319
– Hydrothermale Tiefseeschlote in einer Tiefe von 2.330 m, Ostpazifischer Rücken
- Referenzstamm AL662 alias CNCM I-1319
- Spezies „Thermococcus marinus“ Jolivet et al. 2004
- Referenzstamm EJ1 alias DSM 15227, JCM 11825
– Tiefsee-Hydrothermalschlots am Snake Pit, Mittelatlantischer Rücken
- Referenzstamm EJ1 alias DSM 15227, JCM 11825
- Spezies „Thermococcus petroboostus“ Kapse et al. 2024 [Thermococcus sp. 101 C5]
- Referenzstamm 101C5
– Probe des geförderten Wassers (produziertes Abwasser) einer Erdöllagerstätte in Gujarat, Indien
- Referenzstamm 101C5
- Spezies Thermococcus prieurii Gorlas et al. 2013
- Referenzstamm Bio-pl-0405IT2 alias CSUR P577, JCM 16307
– Probe von einem Tiefsee-Hydrothermalschlot aus 2.700 m Tiefe im Gebiet Sarah Spring, Ostpazifischer Rücken[64]
- Referenzstamm Bio-pl-0405IT2 alias CSUR P577, JCM 16307
- Spezies Thermococcus waiotapuensis González et al. 2001
- Referenzstamm WT1 alias DSM 12768, JCM 10985
– Wai-O-Tapu (Waiotapu hot spring), heiße Süßwasserquelle nahe des Lake Taupō, Neuseeland (Nordinsel)[65]
- Referenzstamm WT1 alias DSM 12768, JCM 10985
- Spezies „Thermococcus mexicalis“ Antoine 1996(N)[66] (nicht in der LPSN)
- Referenzstamm GY 869(N)
– aus heißen hydrothermalen Tiefseesedimenten aus dem Guaymas-Becken, Golf von Kalifornien
- Referenzstamm GY 869(N)
- Spezies Thermococcus sp. 1519(N)[29]
- [Referenz]stamm 1519
– Hydrothermalschlot im Guaymas-Becken, Golf von Kalifornien
- [Referenz]stamm 1519
- Spezies Thermococcus sp. AMT11(N)
- [Referenz]stamm AMT11
– von einem Black-Smoker-Schlot aus 2.400 m Tiefe, Pulsar site, Ostpazifischer Rücken[40]
- [Referenz]stamm AMT11
- Spezies Thermococcus sp. B1001 (N)
- [Referenz]stamm B1001[67][2]
– von einer Thermalquelle in der Präfektur Tottori, Honshū, Japan>[68]
- [Referenz]stamm B1001[67][2]
Phylogenie
| 16S-rRNA-basiert LTP_08_2023[69] | GTDB 08-RS214.[70] | ||||||||||||||||||||||||||||||||||||||||||||||||||||||||||||||||||||||||||||||||||||||||||||||||||||||||||||||||||||||||||||||||||||||||||||||||||||||||||||||||||||||||||||||||||||||||||||||||||||||||||||||||||||||||||||||||||||||||||||||||||||||||||||||||||||||||||||||||||||||||||||||||||||||||||||||||||||||||||||||||||||||||||||||||||||||||||||||||||||||||||||||||||||||||||||||||||||||||||||||||||
|---|---|---|---|---|---|---|---|---|---|---|---|---|---|---|---|---|---|---|---|---|---|---|---|---|---|---|---|---|---|---|---|---|---|---|---|---|---|---|---|---|---|---|---|---|---|---|---|---|---|---|---|---|---|---|---|---|---|---|---|---|---|---|---|---|---|---|---|---|---|---|---|---|---|---|---|---|---|---|---|---|---|---|---|---|---|---|---|---|---|---|---|---|---|---|---|---|---|---|---|---|---|---|---|---|---|---|---|---|---|---|---|---|---|---|---|---|---|---|---|---|---|---|---|---|---|---|---|---|---|---|---|---|---|---|---|---|---|---|---|---|---|---|---|---|---|---|---|---|---|---|---|---|---|---|---|---|---|---|---|---|---|---|---|---|---|---|---|---|---|---|---|---|---|---|---|---|---|---|---|---|---|---|---|---|---|---|---|---|---|---|---|---|---|---|---|---|---|---|---|---|---|---|---|---|---|---|---|---|---|---|---|---|---|---|---|---|---|---|---|---|---|---|---|---|---|---|---|---|---|---|---|---|---|---|---|---|---|---|---|---|---|---|---|---|---|---|---|---|---|---|---|---|---|---|---|---|---|---|---|---|---|---|---|---|---|---|---|---|---|---|---|---|---|---|---|---|---|---|---|---|---|---|---|---|---|---|---|---|---|---|---|---|---|---|---|---|---|---|---|---|---|---|---|---|---|---|---|---|---|---|---|---|---|---|---|---|---|---|---|---|---|---|---|---|---|---|---|---|---|---|---|---|---|---|---|---|---|---|---|---|---|---|---|---|---|---|---|---|---|---|---|---|---|---|---|---|---|---|---|---|---|---|---|---|---|---|---|---|---|---|---|---|---|---|---|---|---|---|---|---|---|---|---|---|---|---|---|---|---|---|---|---|---|---|---|---|---|---|---|---|---|---|---|
Anmerkungen:
|
Anmerkungen:
|
In diesen Phylogenien sind weiterhin noch ohne Zuordnung unter anderem:
- T. coalescens
- T. marinus
- T. waimanguensis
- „T. mexicalis“
Anmerkungen
- ↑ Prionen sind fehlgefaltete Proteine, die in allen Organismen tödliche Krankheiten verursachen können.
- ↑ Kennzeichnung mit hochgestelltem (N).
- ↑ Kennzeichnung mit hochgestelltem (G).
- ↑ nicht in NCBI; in der LPSN nicht als synonym gekennzeichnet, offenbar fehlerhaft
Literatur
- Judicial Commission of the International Committee on Systematics of Prokaryotes: The nomenclatural types of the orders Acholeplasmatales, Halanaerobiales, Halobacteriales, Methanobacteriales, Methanococcales, Methanomicrobiales, Planctomycetales, Prochlorales, Sulfolobales, Thermococcales, Thermoproteales and Verrucomicrobiales are the genera Acholeplasma, Halanaerobium, Halobacterium, Methanobacterium, Methanococcus, Methanomicrobium, Planctomyces, Prochloron, Sulfolobus, Thermococcus, Thermoproteus and Verrucomicrobium, respectively. Opinion 79. In: International Journal of Systematic and Evolutionary Microbiology, Band 55, Nr. 1, Januar 2005, S. 517–518; doi:10.1099/ijs.0.63548-0, PMID 15653928 (englisch).
- Maximilian Mora, Annett Bellack, Matthias Ugele, Johann Hopf, Reinhard Wirth: The temperature gradient-forming device, an accessory unit for normal light microscopes to study the biology of hyperthermophilic microorganisms. In: Applied and Environmental Microbiology. 80. Jahrgang, Nr. 15, August 2014, S. 4764–4770, doi:10.1128/AEM.00984-14, PMID 24858087, PMC 4148812 (freier Volltext), bibcode:2014ApEnM..80.4764M (englisch).
- Paul Villain, Violette da Cunha, Etienne Villain, Patrick Forterre, Jacques Oberto, Ryan Catchpole, Tamara Basta: The hyperthermophilic archaeon Thermococcus kodakarensis is resistant to pervasive negative supercoiling activity of DNA gyrase. In: Nucleic Acids Research, Band 49, Nr. 21, 2. Dezember 2021, S. 12332–12347; doi:10.1093/nar/gkab869, Epub 10. November 2021 (englisch).
Weblinks
- John R. Stevenson: Microbial Evolution and Systematics. In: General Microbiology II. Miami University, Oxford, Ohio. Stand: 4. Februar 2008; Memento im Webarchiv vom 6. Oktober 2008 (englisch).
- BacDive: Genus=Thermococcus
Einzelnachweise
- ↑ Archivo Angels Tapias y Fabrice Confalonieri. Microscopist: Jeril. Original-Dateiname: D9143-ASWCYSt-PU-.tif.
- ↑ a b José Manuel López Nicolás: Reacciones Cotidians. Shackleton books, November 2020. Siehe§ Perfumes duraderos, S. 12–15 (spanisch).
- ↑ a b c LPSN: Genus Thermococcus Zillig 1983.
- ↑ a b GTDB: Thermococcus ….
- ↑ a b
NCBI Taxonomy Browser: Thermococcus. Details: Thermococcus Zillig 1983.
- Daten extrahiert aus NCBI taxonomy resources (FTP), Abgerufen am 19. März 2007
- ↑ a b c d e Francesco Canganella, William J. Jones, Agata Gambacorta, Garabed Antranikian: Thermococcus guaymasensis sp. nov. and Thermococcus aggregans sp. nov., two novel thermophilic archaea isolated from the Guaymas Basin hydrothermal vent site. In: International Journal of Systematic Bacteriology, Band 48, Nr. 4, Oktober 1998, S. 1181–1185; doi:10.1099/00207713-48-4-1181, PMID 9828419 (englisch).
- ↑ a b Gerrit J. Schut, Eric S. Boyd, John W. Peters, Michael W. W. Adams: The modular respiratory complexes involved in hydrogen and sulfur metabolism by heterotrophic hyperthermophilic archaea and their evolutionary implications. In: FEMS Microbiology Reviews. 37. Jahrgang, Nr. 2, März 2013, S. 182–203, doi:10.1111/j.1574-6976.2012.00346.x, PMID 22713092, bibcode:2013FEMMR..37..182S (englisch).
- ↑ a b c Yuusuke Yokooji, Takaaki Sato, Shinsuke Fujiwara, Tadayuki Imanaka, Haruyuki Atomi: Genetic Examination of Initial Amino Acid Oxidation and Glutamate Catabolism in the Hyperthermophilic Archaeon Thermococcus kodakarensis. In: Journal of Bacteriology, Band 195, Nr. 9, 9. April 2013; doi:10.1128/jb.01979-12, PMID 23435976, PMC 3624576 (freier Volltext) (englisch).
- ↑ Haruyuki Atomi, Hiroya Tomita, Takuya Ishibashi, Yuusuke Yokooji, Tadayuki Imanaka: CoA biosynthesis in archaea. In: Biochemical Society Transactions. 41. Jahrgang, Nr. 1, Februar 2013, S. 427–431, doi:10.1042/bst20120311, PMID 23356323 (englisch).
- ↑ a b c Kenta Tagashira, Wakao Fukuda, Masaaki Matsubara, Tamotsu Kanai, Haruyuki Atomi, Tadayuki Imanaka: Genetic studies on the virus-like regions in the genome of hyperthermophilic archaeon, Thermococcus kodakarensis. In: Extremophiles, Band 17, Nr. 1, Januar 2013, S. 153–160; doi:10.1007/s00792-012-0504-6, PMID 23224520 (englisch).
- ↑ a b Tae-Yang Jung, Yae-Sel Kim, Byoung-Ha Oh, Euijeon Woo: Identification of a novel ligand binding site in phosphoserine phosphatase from the hyperthermophilic archaeon Thermococcus onnurineus. In: Wiley Periodicals 11: Proteins, Band 81, Nr. 5, Mai 2013, S. 819–829; doi:10.1002/prot.24238, PMID 23239422, Epub 14. Dezember 2012 (englisch).
- ↑ a b Elisabeth Antoine, Jean Guezennec, Jean-Roch Meunier, Françoise Lesongeur, Georges Barbier: Isolation and Characterization of Extremely Thermophilic Archaebacteria Related to the Genus Thermococcus from Deep-Sea Hydrothermal Guaymas Basin. In: Current Microbiology, Band 31, Nr. 3, September 1995, S. 7; doi:10.1007/bf00293552 (englisch).
- ↑ a b c d e f g Yao Zhang, Zihao Zhao, Chen-Tung Arthur Chen, Kai Tang, Jianqiang Su, Nianzhi Jiao: Sulfur metabolizing microbes dominate microbial communities in Andesite-hosted shallow-sea hydrothermal systems. In: PLOS ONE. 7. Jahrgang, Nr. 9, 7. September 2012, S. e44593, doi:10.1371/journal.pone.0044593, PMID 22970260, PMC 3436782 (freier Volltext), bibcode:2012PLoSO...744593Z (englisch).
- ↑ a b Takashi Itoh: Taxonomy of Nonmethanogenic Hyperthermophilic and Related Thermophilic Archaea. In: Journal of Bioscience and Bioengineering. 96. Jahrgang, Nr. 3, 2003, S. 203–212, doi:10.1263/jbb.96.203, PMID 16233511 (englisch).
- ↑ a b c Yumani Kuba, Sonoko Ishino, Takeshi Yamagami, Masahiro Tokuhara, Tamotsu Kanai, Ryosuke Fujikane, Hiromi Daiyasu, Haruyuki Atomi, Yoshizumi Ishino: Comparative analyses of the two proliferating cell nuclear antigens from the hyperthermophilic archaeon, Thermococcus kodakarensis. In: Genes to Cells, Band 17, Nr. 11, November 2012, S. 923–937; doi:10.1111/gtc.12007, PMID 23078585 (englisch).
- ↑ a b Maximiliano J. Amenábar, Patricio A. Flores, Benoit Pugin, Freddy A. Boehmwald, Jenny M. Blamey: Archaeal diversity from hydrothermal systems of Deception Island, Antarctica. In: Polar Biology. 36. Jahrgang, Nr. 3, 6. Dezember 2013, S. 373–380, doi:10.1007/s00300-012-1267-3, bibcode:2013PoBio..36..373A (englisch).
- ↑ a b c Byung Kwon Kim, Seong Hyuk Lee, Seon-Young Kim, Haeyoung Jeong, Soon-Kyeong Kwon, Choong Hoon Lee, Ju Yeon Song, Dong Su Yu, Sung Gyun Kang, Jihyun F. Kim: Genome sequence of an oligohaline hyperthermophilic archaeon, Thermococcus zilligii AN1, isolated from a terrestrial geothermal freshwater spring. In: Journal of Bacteriology, Band 194, Nr. 14, Juli 2012, S. 3765–3766; doi:10.1128/jb.00655-12, PMID 22740682, PMC 3393502 (freier Volltext) (englisch).
- ↑ Mart Krupovic, Mathieu Gonnet, Wajdi Ben Hania, Patrick Forterre, Gaël Erauso: Insights into dynamics of mobile genetic elements in hyperthermophilic environments from five new Thermococcus plasmids. In: PLOS ONE, Band 8, Nr. 1, 11. Januar 2013, S. e49044; doi:10.1371/journal.pone.0049044, PMID 23326305, PMC 3543421 (freier Volltext), bibcode:2013PLoSO...849044K (englisch).
- ↑ Adrian Hetzer, Hugh W. Morgan, Ian R. McDonald, Christopher J. Daughney: Microbial life in Champagne Pool, a geothermal spring in Waiotapu, New Zealand. In: Extremophiles. 11. Jahrgang, Nr. 4, Juli 2007, S. 605–614, doi:10.1007/s00792-007-0073-2, PMID 17426919 (englisch).
- ↑ Kazuo Tori, Sonoko Ishino, Shinichi Kiyonari, Saki Tahara, Yoshizumi Ishino: A novel single-strand specific 3'-5' exonuclease found in the hyperthermophilic archaeon, Pyrococcus furiosus. In: PLOS ONE, Band 8, Nr. 3, 7. März 2013, S. e58497; doi:10.1371/journal.pone.0058497, PMID 23505520, PMC 3591345 (freier Volltext), bibcode:2013PLoSO...858497T (englisch).
- ↑ a b Lubomira Čuboňová, Masahiro Katano, Tamotsu Kanai, Haruyuki Atomi, John N. Reeve, Thomas J. Santangelo: An archaeal histone is required for transformation of Thermococcus kodakarensis. In: Journal of Bacteriology, Band 194, Nr. 24, Dezember 2012, S. 6864–6874; doi:10.1128/jb.01523-12, PMID 23065975, PMC 3510624 (freier Volltext) (englisch).
- ↑ Anne Postec, Françoise Lesongeur, Patricia Pignet, Bernard Ollivier, Joël Querellou, Anne Godfroy: Continuous enrichment cultures: insights into prokaryotic diversity and metabolic interactions in deep-sea vent chimneys. In: Extremophiles. 11. Jahrgang, Nr. 6, November 2007, hdl:20.500.11850/58941, S. 747–757, doi:10.1007/s00792-007-0092-z, PMID 17576518 (englisch).
- ↑ Jed O. Eberly, Roger L. Ely: Thermotolerant hydrogenases: biological diversity, properties, and biotechnological applications. In: Critical Reviews in Microbiology. 34. Jahrgang, Nr. 3–4, 2. Dezember 2008, S. 117–130, doi:10.1080/10408410802240893, PMID 18728989 (englisch).
- ↑ a b Zhicheng Cui, Yuhan Wang, Bang Phuong Pham, Fangfang Ping, Hongyu Pan, Gang-Won Cheong, Shihong Zhang, Baolei Jia: High level expression and characterization of a thermostable lysophospholipase from Thermococcus kodakarensis KOD1. In: Extremophiles. 16. Jahrgang, Nr. 4, Juli 2012, S. 619–625; doi:10.1007/s00792-012-0461-0, PMID 22622648 (englisch).
- ↑ a b c d Yukiko Ozawa, Masood Ahmed Siddiqui, Yasufumi Takahashi, Akio Urushiyama, Daijiro Ohmori, Fumiyuki Yamakura, Fumio Arisaka, Takeo Imai: Indolepyruvate ferredoxin oxidoreductase: An oxygen-sensitive iron-sulfur enzyme from the hyperthermophilic archaeon Thermococcus profundus. In: Journal of Bioscience and Bioengineering, Band 114, Nr. 1, Juli 2012, S. 23–27; doi:10.1016/j.jbiosc.2012.02.014, PMID 22608551 (englisch).
- ↑ a b c d e Irene A. Davidova, Kathleen E. Duncan, B. Monica Perez-Ibarra, Joseph M. Suflita: Involvement of thermophilic archaea in the biocorrosion of oil pipelines. In: Environmental Microbiology. 14. Jahrgang, Nr. 7, Juli 2012, S. 1762–1771, doi:10.1111/j.1462-2920.2012.02721.x, PMID 22429327, bibcode:2012EnvMi..14.1762D (englisch).
- ↑ Anne M. Brown, Samantha L. Hoopes, Robert H. White, Catherine A. Sarisky: Purine biosynthesis in archaea: variations on a theme. In: Biology Direct. 6. Jahrgang, Dezember 2011, S. 63, doi:10.1186/1745-6150-6-63, PMID 22168471, PMC 3261824 (freier Volltext) – (englisch).
- ↑ a b Guy D. Duffaud, Olga B. d'Hennezel, Andrew S. Peek, Anna-Louise Reysenbach, Robert M. Kelly: Isolation and characterization of Thermococcus barossii, sp. nov., a hyperthermophilic archaeon isolated from a hydrothermal vent flange formation. In: Systematic and Applied Microbiology, 21. Jahrgang, Nr. 1, März 1998, S. 40–49; doi:10.1016/s0723-2020(98)80007-6, PMID 9741109, bibcode:1998SyApM..21...40D (englisch).
- ↑ a b Tatiana E. Petrova, Ekaterina Yu Bezsudnova, Konstantin M. Boyko, A. V. Mardanov, K. M. Polyakov, V. V. Volkov, M. Kozin, N. V. Ravin, I. G. Shabalin, K. G. Skryabin, Tatiana N. Stekhanova, Michael V. Kovalchuk, Vladimir O. Popov: ATP-dependent DNA ligase from Thermococcus sp. 1519 displays a new arrangement of the OB-fold domain. In: Acta Crystallographica. Section F, Structural Biology and Crystallization Communications, Band 68, Nr. 12, Dezember 2012, S. 1440–1447; doi:10.1107/s1744309112043394, PMID 23192021, PMC 3509962 (freier Volltext) (englisch).
- ↑ a b c Jan P. Amend: A brief review of microbial geochemistry in the shallow-sea hydrothermal system of Vulcano Island (Italy). In: Freiberg Online Geoscience. 22. Jahrgang, Januar 2009, ResearchGate:287480810, S. 7 (englisch).
- ↑ a b Ronny C. Hughes, Leighton Coates, Matthew P. Blakeley, Steve J. Tomanicek, Paul Langan, Andrey Y. Kovalevsky, Juan M. García-Ruiz, Joseph D. Ng: Inorganic pyrophosphatase crystals from Thermococcus thioreducens for X-ray and neutron diffraction. In: Acta Crystallographica, Section F, Structural Biology and Crystallization Communications, Band 68. Jahrgang, Nr. 12, Dezember 2012, S. 1482–1487; doi:10.1107/S1744309112032447, PMID 23192028, PMC 3509969 (freier Volltext) (englisch).
- ↑ a b Haruyuki Atomi, John Reeve: Microbe Profile: Thermococcus kodakarensis: the model hyperthermophilic archaeon. In: Microbiology, Band 165, Nr. 11, November 2019, S. 1166–1168; doi:10.1099/mic.0.000839, PMID 31436525, PMC 7137780 (freier Volltext) (englisch).
- ↑ Håkon Dahle, Frøydis Garshol, Marit Madsen & Nils-Kåre Birkeland: Microbial community structure analysis of produced water from a high-temperature North Sea oil-field. In: Antonie van Leeuwenhoek, Band 93, Nr. 13, 2008, S. 37–49; doi:10.1007/s10482-007-9177-z, PMID 17588160, Epub 22. Juni 2007 (englisch).
- ↑ a b c d e f g Evelyne Marguet, Marie Gaudin, Emilie Gauliard, Isabelle Fourquaux, Stephane le Blond du Plouy, Ikuo Matsui, Patrick Forterre: Membrane vesicles, nanopods and/or nanotubes produced by hyperthermophilic archaea of the genus Thermococcus. In: Biochemical Society Transactions, Band 41, Nr. 1, Februar 2013, S. 436–442; doi:10.1042/bst20120293, PMID 23356325 (englisch).
- ↑ a b c d e Emilie Gauliard, Stefan Schouten, Ludivine Houel-Renault, Pascal Lenormand, Evelyne Marguet, Patrick Forterre: Hyperthermophilic archaea produce membrane vesicles that can transfer DNA. In: Environmental Microbiology Reports. 5. Jahrgang, Nr. 1, Februar 2013, S. 109–116, doi:10.1111/j.1758-2229.2012.00348.x, PMID 23757139, bibcode:2013EnvMR...5..109G (englisch).
- ↑ a b Tomohiko Kuwabara, Masaomi Minaba, Yukihiro Iwayama, Isao Inouye, Miwako Nakashima, Katsumi Marumo, Akihiko Maruyama, Akihiko Sugai, Toshihiro Itoh, Jun-Ichiro Ishibashi, Tetsuro Urabe, Masahiro Kamekura: Thermococcus coalescens sp. nov., a cell-fusing hyperthermophilic archaeon from Suiyo Seamount. In: InternationalJournal of Systematic and Evolutionary Microbiology, Band 55, Nr. 6, 1. November 2005, S. 2507–2514; doi:10.1099/ijs.0.63432-0, PMID 16280518 (englisch).
- ↑ Zhuo Li, Lori M. Kelman, Zvi Kelman: Thermococcus kodakarensis DNA replication. In: Biochemical Society Transactions, Band 41, Nr. 1, Februar 2013, S. 332–8; doi:10.1099/00207713-48-1-23, PMID 23356307 (englisch).
- ↑ a b c d e Azumi Hirata, Yuki Hori, Yuichi Koga, Jun Okada, Akikazu Sakudo, Kazuyoshi Ikuta, Shigenori Kanaya, Kazufumi Takano: Enzymatic activity of a subtilisin homolog, Tk-SP, from Thermococcus kodakarensis in detergents and its ability to degrade the abnormal prion protein. In: BMC Biotechnology, Band 13, Februar 2013, S. 19; doi:10.1186/1472-6750-13-19, PMID 23448268, PMC 3599501 (freier Volltext) (englisch).
- ↑ Ryo Uehara, Shun-ichi Tanaka, Kazufumi Takano, Yuichi Koga, Shigenori Kanaya: Requirement of insertion sequence IS1 for thermal adaptation of Pro-Tk-subtilisin from hyperthermophilic archaeon. In: Extremophiles. 16. Jahrgang, Nr. 6, November 2012, S. 841–51, doi:10.1007/s00792-012-0479-3, PMID 22996828 (englisch).
- ↑ a b Mathieu Gonnet, Gaël Erauso, Daniel Prieur, Marc Le Romancer: pAMT11, a novel plasmid isolated from a Thermococcus sp. strain closely related to the virus-like integrated element TKV1 of the Thermococcus kodakaraensis genome. In: Research in Microbiology, Band 162, Nr. 2, Februar–März 2011, S. 132–143; doi:10.1016/j.resmic.2010.11.003, PMID 21144896 (englisch).
- ↑ a b
Aurore Gorlas, Eugene V. Koonin, Nadège Bienvenu, Daniel Prieur, Claire Geslin: TPV1, the first virus isolated from the hyperthermophilic genus Thermococcus. In: Environmental Microbiology, Special Issue: Taxonomy and Biodiversity, Band 14, Nr. 2, Februar 2012, S. 503–516; doi:10.1111/j.1462-2920.2011.02662.x, PMID 22151304, PMC 5935114 (freier Volltext) (englisch). Dazu:
- F. Orange, A. Chabin, Aurore Gorlas, S. Lucas-Staat, Claire Geslin, M. Le Romancer, David Prangishvili, Patrick Forterre, F. Westall: Experimental fossilisation of viruses from extremophilic Archaea. In: Biogeosciences Discuss., Band 8, 4. März 2011, S. 2235–2257; doi:10.5194/bgd-8-2235-2011 (englisch).
- ↑ NCBI Taxonomy Browser: Thermococcus prieurii virus 1.
- ↑ NCBI Taxonomy Browser: Pyrococcus abyssi virus 1.
- ↑ a b Hyewoo Ppyun, Inhye Kim, Sung Suk Cho, Kang Jin Seo, Keejung Yoon, Suk-Tae Kwon: Improved PCR performance using mutant Tpa-S DNA polymerases from the hyperthermophilic archaeon Thermococcus pacificus. In: Journal of Biotechnology, Band 164, Nr. 2, Dezember 2012, S. 363–370; doi:10.1016/j.jbiotec.2013.01.022, PMID 23395617 (englisch).
- ↑ a b c Anton A. Trofimov, Elvira A. Slutskaya, Konstantin M. Polyakov, Pavel V. Dorovatovskii, Vadim M. Gumerov, Vladimir O. Popov: Influence of intermolecular contacts on the structure of recombinant prolidase from Thermococcus sibiricus. In: Acta Crystallographica. Section F, Structural Biology and Crystallization Communications, Band 68, Nr. 11, November 2012, S. 1275–1278; doi:10.1107/s174430911203761x, PMID 23143231, PMC 3515363 (freier Volltext) (englisch).
- ↑ O-Phospho-L-Serin. Auf: Merck Sigma-Aldrich.
- ↑ Wolfram Zillig, Ingelore Holz, Davorin Janekovic, W. Schäfer, W. D. Reiter: The archaebacterium Thermococcus celer represents a novel genus within the thermophilic branch of the archaebacteria. In: Syst. Appl. Microbiol., Band 4, Nr. 1, Januar 1983, S. 88–94; doi:10.1016/S0723-2020(83)80036-8, PMID 23196302, bibcode:1983SyApM...4...88Z (englisch).
- ↑ a b Porto di Levante (Vulcano). Auf Google Maps.
- ↑ a b Margarita L. Miroshnichenko, Gregory M. Gongadze, Fred A. Rainey, Alla S. Kostyukova, Anatoly M. Lysenko, Nikolai Alexeevitch Chernyh, Elizaveta A. Bonch-Osmolovskaya: Thermococcus gorgonarius sp. nov. and Thermococcus pacificus sp. nov.: heterotrophic extremely thermophilic archaea from New Zealand submarine hot vents. In: Int. J. Syst. Bacteriol. Band 48, Nr. Pt 1, 1. Januar 1998, S. 23–29; doi:10.1099/00207713-48-1-23, PMID 9542072 (englisch).
- ↑ Onnuri vent field, Central Indian Ridge, Indian Ocean, auf mindat.org (englisch).
- ↑ Haruyuki Atomi, Toshiaki Fukui, Tamotsu Kanai, Masaaki Morikawa, Tadayuki Imanaka: Description of Thermococcus kodakaraensis sp. nov., a well studied hyperthermophilic archaeon previously reported as Pyrococcus sp. KOD1. In: Archaea, Band 1, Nr. 4, Oktober 2004, S. 263–267; doi:10.1155/2004/204953, PMC 2685570 (freier Volltext). PMID 15810436, Epub 16. April 2004 (englisch).
- ↑ Wakao Fukuda, Yulia Sari Ismail, Toshiaki Fukui, Haruyuki Atomi, Tadayuki Imanaka: Characterization of an archaeal malic enzyme from the hyperthermophilic archaeon Thermococcus kodakaraensis KOD1. In: Archaea, Band 1, Nr. 5, Mai 2005, S. 293–301; doi:10.1155/2005/250757, PMID 15876562, PMC 2685551 (freier Volltext) (englisch).
- ↑ Toshiaki Fukui, Haruyuki Atomi, Tamotsu Kanai, Rie Matsumi, Shinsuke Fujiwara, Tadayuki Imanaka: Complete genome sequence of the hyperthermophilic archaeon Thermococcus kodakaraensis KOD1 and comparison with Pyrococcus genomes. In: CSH Press: Genome Research, Band 15, Nr. 3, März 2005, S. 352–363; doi:10.1101/gr.3003105, PMID 15710748, PMC 551561 (freier Volltext), Epub 14. Februar 2005 (englisch).
- ↑ Nathan E. Kreel, F. Robert Tabita: Serine 363 of a Hydrophobic Region of Archaeal Ribulose 1,5-Bisphosphate Carboxylase/Oxygenase from Archaeoglobus fulgidus and Thermococcus kodakaraensis Affects CO2/O2 Substrate Specificity and Oxygen Sensitivity. In: PLOS ONE 18. September 2015; doi:10.1371/journal.pone.0138351, ResearchGate:282043257 (englisch).
- ↑ Muhammad Atif Nisar, Naeem Rashid, Qamar Bashir, Qurra-tul-Ann Afza Gardner, Muhammad Hassan Shafiq, Muhammad Akhtar: TK1299, a highly thermostable NAD(P)H oxidase from Thermococcus kodakaraensis exhibiting higher enzymatic activity with NADPH. In: Journal of Bioscience and Bioengineering, Band 116, Nr. 1, Juli 2013, S. 39–44; doi:10.1016/j.jbiosc.2013.01.020, PMID 23453203 (englisch).
- ↑ Masaaki Morikawa, Yoshifumi Izawa, Naeem Rashid, Toshihiro Hoaki, Tadayuki Imanaka: Purification and characterization of a thermostable thiol protease from a newly isolated hyperthermophilic Pyrococcus sp. In: Applied and Environmental Microbiology. 60. Jahrgang, Nr. 12, Dezember 1994, S. 4559–4566, doi:10.1128/aem.60.12.4559-4566.1994, PMID 7811092, PMC 202019 (freier Volltext) – (englisch).
- ↑
Nicolas Soler, Anthony Justome, Sophie Quevillon-Cheruel, Florence Lorieux, Eric Le Cam, Evelyne Marguet, Patrick Forterre: The rolling-circle plasmid pTN1 from the hyperthermophilic archaeon Thermococcus nautilus. In: Wiley: Molecular Microbiology, Band 66, Nr. 2, Oktober 2007. S. 357–370; doi:10.1111/j.1365-2958.2007.05912.x, Epub 14. September 2007 (englisch).
Anmerkung: Im Text (§Results) wird erwähnt, dass es um den Stamm 30-1 geht. - ↑ PACMANUS hydrothermal field, Manus Basin, Bismarck Sea, Papua New Guinea, auf mindat.org (englisch).
- ↑ RV ONNURI, auf: Maritime Hawai‘i (maritimehawaii.com).
- ↑ Bukhta Kraternaya. Auf: Mapcarta (de).
- ↑ Philippe Oger, Tatyana G. Sokolova, Darya A. Kozhevnikova, Nikolai A. Chernyh, Douglas H. Bartlett, Elizaveta A. Bonch-Osmolovskaya, Alexander V. Lebedinsky: Complete Genome Sequence of the Hyperthermophilic Archaeon Thermococcus sp. Strain AM4, Capable of Organotrophic Growth and Growth at the Expense of Hydrogenogenic or Sulfidogenic Oxidation of Carbon Monoxide. In: ASM Journals: Journal of Bacteriology, Band 193, Nr. 24, 28. November 2011; doi:10.1128/jb.06259-11, PMID 22123768, PMC 3232831 (freier Volltext) (englisch).
- ↑
Palaeochori-Bucht (Paralia Paliochóri), Milos
- Paliochóri. Auf: Mapcarta (de),
- Paralia Paleochori (Paliochori beach). Auf: Google Maps.
- ↑ Fidschi-Becken <Nord>, Index-Eintrag in HEIDI, Katalog für die Bibliotheken der Universität Heidelberg.
- ↑ Aurore Gorlas, Karine Alain, Nadège Bienvenu, Claire Geslin: Thermococcus prieurii sp. nov., a hyperthermophilic archaeon isolated from a deep-sea hydrothermal vent. In: International Journal of Systematic and Evolutionary Microbiology, Band 63, Nr. 8, 1. August 2013; doi:10.1099/ijs.0.026419-0, PMID 23355695, Epub 25. Januar 2013 (englisch).
- ↑ Mark C. Capece, Evan Clark, Jamal K. Saleh, Daniel Halford, Nicole Heinl, Samuel Hoskins, Lynn J. Rothschild: Polyextremophiles and the Constraints for Terrestrial Habitability. In: Joseph Seckbach, Aharon Oren, Helga Stan-Lotter (Hrsg.): Polyextremophiles, Band 27, 1. Januar 2013, S. 3–59; doi:10.1007/978-94-007-6488-0 1, ResearchGate:278659206, Epub April 2013 (englisch).
- ↑ Elisabeth Antoine: Thermococcus mexicalis sp. nov., a new thermophilic Archaebacteria isolated from hot deep-sea hydrothermal sediments from the Gaymas (sic) [Guaymas] Basin. in: NCBI Taxonomy Browser: Thermococcus mexicalis, homotypic synonym: 'Thermococcus mexicalis'. Unpublished (as of 23 July 1996).
- ↑ Yoshiteru Hashimoto, Tomoko Yamamoto, Shinsuke Fujiwara, Masahiro Takagi, Tadayuki Imanaka: Extracellular Synthesis, Specific Recognition, and Intracellular Degradation of Cyclomaltodextrins by the Hyperthermophilic Archaeon Thermococcus sp. Strain B1001. In: ASM Jourbals: Journal of Bacteriology, Band 183, Nr. 17, 1. September 2001, S. 5050–5057; doi:10.1128/JB.183.17.5050-5057.2001, PMC 95380 (freier Volltext), PMID 11489857 (englisch).
- ↑ Yoshihisa Tachibana, Akiko Kuramura, Naoki Shirasaka, Yuji Suzuki, Tomoko Yamamoto, Shinsuke Fujiwara, Masahiro Takagi, Tadayuki Imanaka: Purification and Characterization of an Extremely Thermostable Cyclomaltodextrin Glucanotransferase from a Newly Isolated Hyperthermophilic Archaeon, a Thermococcus sp. In: ASM Journals: Applied and Environmental Microbiology, Band 65, Nr. 5, 1. Mai 1999,S. 1991–1997; doi:10.1128/aem.65.5.1991-1997.1999, PMC 91287 (freier Volltext), PMID 10223990 (englisch).
- ↑
The LTP. In: The All-Species Living Tree Project. Abgerufen am 20. November 2023 (englisch).
- Tree: LTP_all_08_2023 (Newick-Format). In: , Abgerufen am 20. November 2023
- LTP_08_2023 Release Notes. Abgerufen am 20. November 2023 (englisch).
- ↑
GTDB release 08-RS214. In: Genome Taxonomy Database. Abgerufen am 10. Mai 2023 (englisch).
- Tree: ar53_r214.sp_label (Newick-Format). In: Genome Taxonomy Database, Abgerufen am 10. März 2007.
- Taxon History. In: Genome Taxonomy Database. Abgerufen am 20. Mai 2023 (englisch).